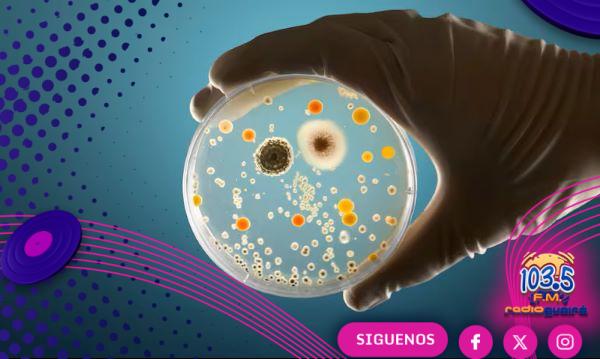

Principal sospechoso del caso Madeleine McCann fue liberado en Alemania Principal sospechoso del caso Madeleine McCann fue liberado en Alemania
El principal sospechoso de la desaparición de la niña británica Madeleine McCann en 2007 en Portugal, Christian Brückner, salió de prisión en Alemania este miércoles después de cumplir una [...]